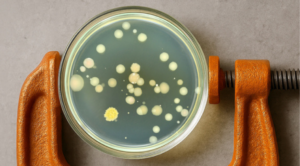
Stressbewältigung im Mikrokosmos – Was wir von Bakterien lernen können

Kontakt
Gabriela Szobonyová
Assistentin der Geschäftsführung, Eventmanagement
+49 641 94888912
Email schreiben

Wo Vernetzung Erfolg schafft
Entdecken Sie unsere regionalen Netzwerk-Events: Hier treffen Fachthemen auf wertvolle Kontakte. Gemeinsam fördern wir regionale Kooperationen und schaffen neue Chancen. Tauschen Sie sich aus, finden Sie neue Partner oder Inspiration.
Ob Startup Weekend, Innovationsforum, Regionalforum Personalmanagement oder TeamMit Live: Hier ist für jeden etwas dabei.
Filtern Sie einfach nach Ihren gewünschten Kategorien.

28. April 2026
- Regionalmanagement Events
mittelhessen GESTALTEN: Das Forum für Innovations- und Personalmanagement
9:30 - 17:00 Mehr erfahren
29. Mai 2026 - 31. Mai 2026
- Regionalmanagement Events
Startup Weekend Mittelhessen 2026
16:30 - 20:30 Mehr erfahren
16. April 2026
- TeamMit Events
Tag des Changes 2026 – Verhalten. Verstehen. Verändern.
9:00 - 14:00 Mehr erfahren

5. Mai 2026
- TeamMit Events
Energie effizient nutzen, Klimaziele erreichen
10:00 - 11:00 Mehr erfahren


2. Juni 2026
- TeamMit Events
Internationalisierung & Partnering mit dem Enterprise Europe Network
11:00 - 12:00 Mehr erfahren
11. Juni 2026
- TeamMit Events
Betrieb sichern, Zukunft gestalten – Orientierung in bewegten Zeiten
9:30 - 14:30 Mehr erfahren

17. Juni 2026
- TeamMit Events
Digitale Souveränität im Mittelstand stärken
10:00 - 12:00 Mehr erfahren


14. September 2026
- TeamMit Events
Bildungsforum 2026 – Transformation im Bildungswesen
14:00 - 18:00 Mehr erfahren
23. Oktober 2026
- TeamMit Events
Lernpfad: Bewusst und wirkungsvoll kommunizieren
10:00 - 11:00 Mehr erfahren

21. April 2026
- MINTmit Events
Mathe-Detektive – Neuster Fall: Die Reise in die Unendlichkeit
14:00 - 17:00 Mehr erfahren

28. April 2026
- MINTmit Events
MINtplus Identität: Warum bin ich, wie ich bin?
16:00 - 17:30 Mehr erfahren




21. Mai 2026
- MINTmit Events
Mathe-Detektive – Neuster Fall: Das mathematische Geheimnis von Dobble
8:00 - 17:00 Mehr erfahren
21. Mai 2026
- MINTmit Events
MarBiNa-Nachwuchspreis – Neuer MINT-Forschungspreis
14:30 - 20:00 Mehr erfahren



23. Juni 2026
- MINTmit Events
MINTplus Wetter: Wenn Regentropfen Neugier wecken
16:00 - 17:30 Mehr erfahren


15. September 2026
- MINTmit Events
Neue Antibiotika – Der geniale Baukasten der Mikroben
15:30 - 16:30 Mehr erfahren
29. September 2026
- MINTmit Events
Stressbewältigung im Mikrokosmos – Was wir von Bakterien lernen können
15:30 - 16:30 Mehr erfahren
Sie haben ein Event verpasst?
In unseren News berichten wir im Nachgang darüber, schauen Sie doch mal vorbei!

DER MITTELHESSEN-INFOLETTER
Frische News aus der Region, immer zum Monatsanfang: Aktuelles, Events, Neues aus Wirtschaft, Wissenschaft und Bildung.